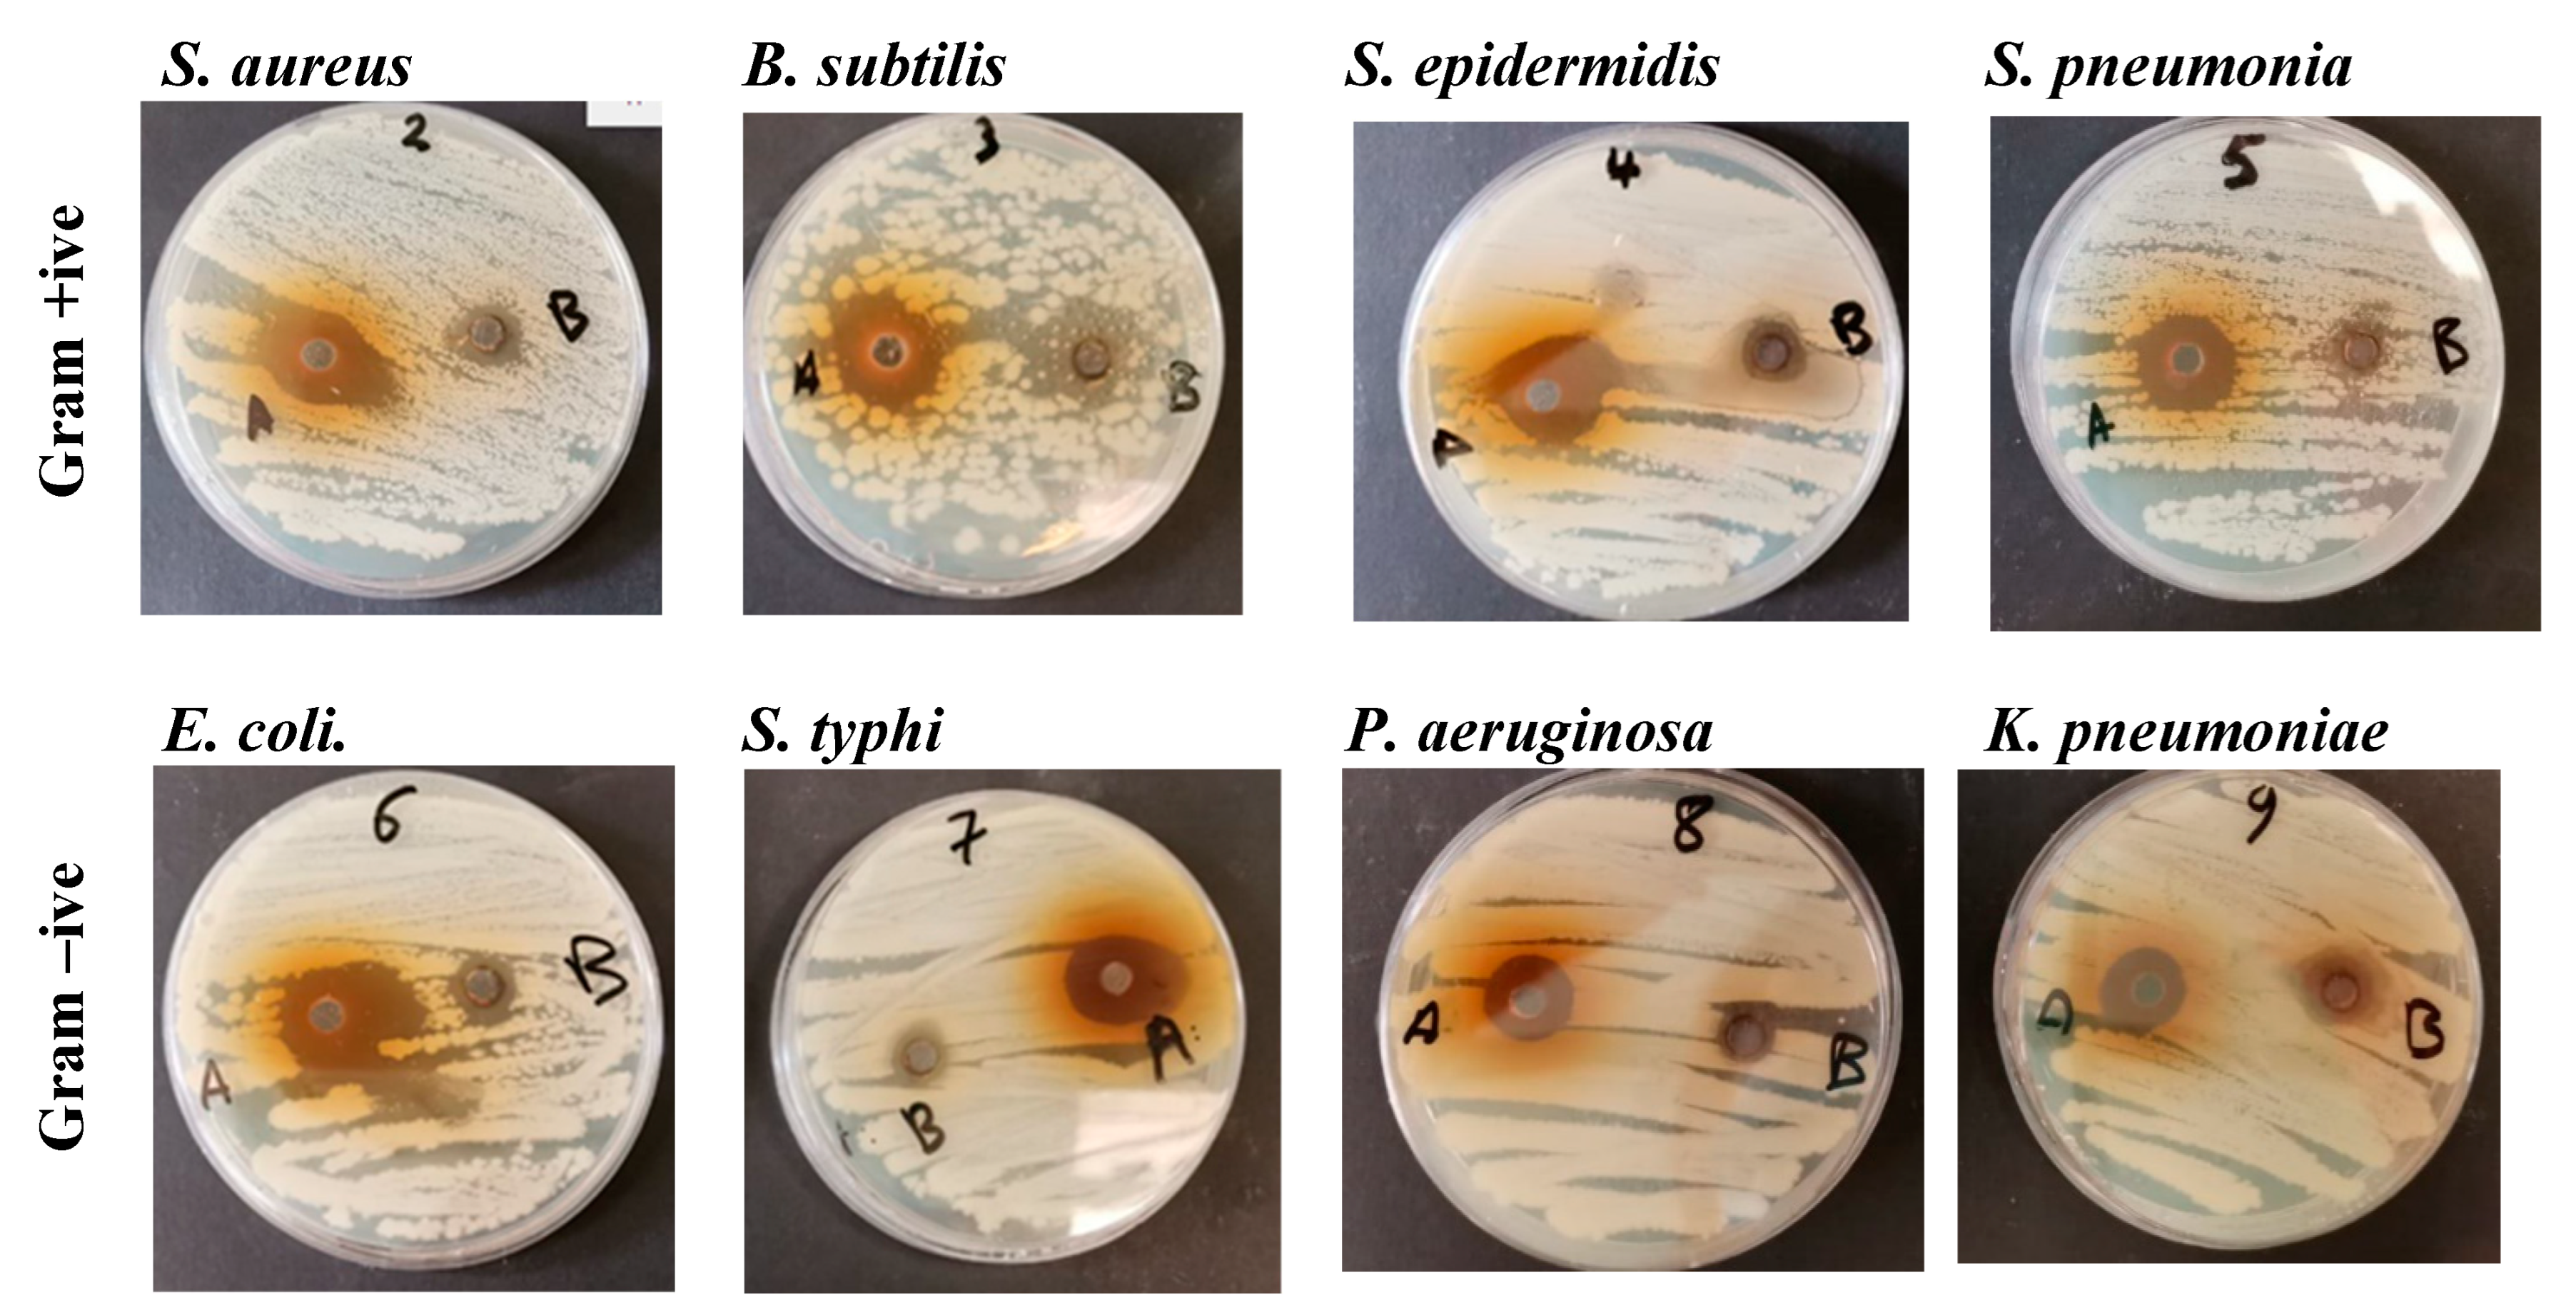

Anticancer and Antimicrobial Activity of Silver Nanoparticles Synthesized from Pods of Acacia nilotica
Abstract
1. Introduction
2. Materials and Methods
2.1. A. nilotica Pods Extract
2.2. Preparation of Silver Nanoparticles
2.3. Characterization of A. nilotica-AgNPs
2.4. UV/Vis Spectroscopic Analysis
2.5. Scanning Electron Microscope (SEM) and Transmission Electron Microscopy (TEM)
2.6. Average Particles Size and Zeta Potential Analysis
2.7. Fourier-Transformed Infrared Spectroscopy (FTIR)
2.8. Antibacterial Activity
2.9. Cytotoxic Activity
2.10. Gene Expression
2.11. Statistical Analysis
3. Results and Discussion
3.1. Green Synthesis of Silver Nanoparticles
3.2. Characterization of A. nilotica-AgNPs
3.3. Fourier-Transformed Infrared (FTIR)
3.4. Antibacterial Activity
3.5. Cytotoxic Activity
3.6. Gene Expression
4. Conclusions
Author Contributions
Funding
Data Availability Statement
Acknowledgments
Conflicts of Interest
References
- Khan, I.; Khan, K.S.I. Nanoparticles; Properties, applications, and toxicities. Arab. J. Chem. 2019, 12, 908–931. [Google Scholar] [CrossRef]
- Yusuf, M. Silver Nanoparticles: Synthesis and Applications. Handbook of Ecomaterials. 2018, 2343–2356. [Google Scholar] [CrossRef]
- Khosravimelal, S.; Chizari, M.; Farhadihosseinabadi, B.; Moghaddam, M.M.; Gholipourmalekabadi, M. Fabrication and characterization of an antibacterial chitosan/silk fibroin electrospun nanofiber loaded with a cationic peptide for wound-dressing application. J. Mater. Sci. Mater. Med. 2021, 32, 114. [Google Scholar] [CrossRef]
- Yaqoob, A.A.; Ahmad, H.; Parveen, T.; Ahmad, A.; Oves, M.; Ismail, I.M.I.; Qari, H.A.; Umar, K.; MohamadIbrahim, M.N. Recent Advancesin Metal Decorated Nanomaterials andTheir Various Biological Applications: A Review. Front. Chem. 2020, 8, 341. [Google Scholar] [CrossRef]
- Hasan, S. A review on nanoparticles: Their synthesis and types. Res. J. Recent Sci. 2015, 4, 1–3. [Google Scholar]
- Bhat, R.S.; Almusallam, J.; Al Daihan, S.; Al-Dbass, A. Biosynthesisof silver nanoparticles using Azadirachta indica leaves:characterisation and impact on Staphylococcus aureus growthand glutathione-S-transferase activity. IET Nanobiotechnol. 2019, 13, 498–502. [Google Scholar] [CrossRef]
- Al-Zahrani, S.A.; Bhat, R.S.; Al Rashed, S.A.; Mahmood, A.; Al Fahad, A.; Alamro, G.; Almusallam, J.; Al Subki, R.; Orfali, R.; Al Daihan, S. Green-synthesized silver nanoparticles with aqueous extract of green algae Chaetomorpha ligustica and its anticancer potential. Green Process. Synth. 2021, 10, 711–721. [Google Scholar] [CrossRef]
- Daghestani, M.; Al Rashed, S.A.; Bukhari, W.; Al-Ojayan, B.; Ibrahim, E.M.; Al-Qahtani, A.M.; Merghani, N.M.; Ramadan, R.; Bhat, R.S. Bactericidal and cytotoxic properties of green synthesized nanosilver using Rosmarinus officinalis leaves. Green Process Synth. 2020, 9, 230–236. [Google Scholar] [CrossRef]
- El-Ansary, A.; Warsy, A.; Daghestani, M.; Merghani, N.M.; Al-Dbass, A.; Bukhari, W. Characterization, antibacterial, and neurotoxic effect of green synthesized nanosilver using Ziziphus spina Christi aqueous leaf extract collected from Riyadh, Saudi Arabia. Mater. Res. Exp. 2018, 5, 025033. [Google Scholar] [CrossRef]
- Sayadi, K.; Akbarzadeh, F.; Pourmardan, V.; Saravani-Aval, M.; Sayadi, J.; Chauhan, N.P.S.; Sargazi, G. Methods of green synthesis of Au NCs with emphasis on their morphology: A mini-review. Heliyon 2021, 7, e07250. [Google Scholar] [CrossRef] [PubMed]
- Qing, Y.; Cheng, L.; Li, R.; Liu, G.; Zhang, Y.; Tang, X.; Wang, J.; Liu, H.; Qin, Y. Potential antibacterial mechanism of silver nanoparticles and the optimization of orthopedic implants by advanced modification technologies. Int. J. Nanomed. 2018, 13, 3311–3327. [Google Scholar] [CrossRef] [PubMed]
- Kovács, D.; Igaz, N.; Gopisetty, M.K.; Kiricsi, M. CancerTherapy by Silver Nanoparticles:Fiction or Reality? Int. J. Mol. Sci. 2022, 23, 839. [Google Scholar] [CrossRef] [PubMed]
- Chen, Y.; Yang, T.; Chen, S.; Qi, S.; Zhang, Z.; Xu, Y. Silver nanoparticles regulate autophagy through lysosome injury and cell hypoxia in prostate cancer cells. J. Biochem. Mol. Toxicol. 2020, 34, e22474. [Google Scholar] [CrossRef]
- Simard, J.-C.; Durocher, I.; Girard, D. Silver nanoparticles induce irremediable endoplasmic reticulum stress leading to unfolded protein response-dependent apoptosis in breast cancer cells. Apoptosis 2016, 21, 1279–1290. [Google Scholar] [CrossRef]
- Gherasim, O.; Puiu, R.A.; Birca, A.C.; Burdusel, A.C.; Grumezescu, A.M. An updated review on silver nanoparticles in biomedicine. Nanomaterials 2020, 10, 2318. [Google Scholar] [CrossRef]
- Kong, I.C.; Ko, K.S.; Koh, D.C. Evaluation of the Effects of Particle Sizes of Silver Nanoparticles on Various Biological Systems. Int. J. Mol. Sci. 2020, 21, 8465. [Google Scholar] [CrossRef]
- Wang, L.; Hu, C.; Shao, L. The antimicrobial activity of nanoparticles: Present situation and prospects for the future. Int. J. Nanomed. 2017, 12, 1227–1249. [Google Scholar] [CrossRef]
- Kruszewski, M.; Brzoska, K.; Brunborg, G.; Asare, N.; Dobrzynska, M.; Dusinská, M.; Fjellsbř, L.; Georgantzopoulou, A.; Gromadzka-Ostrowska, J.; Gutleb, A.; et al. Toxicity of silver nanomaterials in higher eukaryotes. Adv. Mol. Toxicol. 2011, 5, 179–218. [Google Scholar]
- Fu, P.P.; Xia, Q.; Hwang, H.M.; Ray, P.C.; Yu, H. Mechanisms of nanotoxicity: Generation of reactive oxygen species. J. Food Drug Anal. 2014, 22, 64–75. [Google Scholar] [CrossRef]
- Rinna, A.; Magdolenova, Z.; Hudecova, A.; Kruszewski, M.; Refsnes, M.; Dusinska, M. Effect of silver nanoparticles on mitogen-activated protein kinases activation: Role of reactive oxygen species and implication in DNA damage. Mutagenesis 2015, 30, 59–66. [Google Scholar] [CrossRef] [PubMed]
- Rizwana, H.; Alwhibi, M.S.; Aldarsone, H.A.; Awad, M.A.; Soliman, D.A.; Bhat, R.S. Green synthesis, characterization, and antimicrobial activity of silver nanoparticle prepared using Trigonella foenum-graecum L. leaves grown in Saudi Arabia. Green Process. Synth. 2021, 10, 421–429. [Google Scholar] [CrossRef]
- Almukaynizi, F.B.; Daghestani, M.H.; Awad, M.A.; Althomali, A.; Merghani, N.M.; Bukhari, W.I.; Algahtani, N.M.; Al-Zuhairy, S.S.; ALOthman, A.M.; Alsenani, E.A.; et al. Cytotoxicity of green-synthesized silver nanoparticles by Adansonia digitata fruit extract against HTC116 and SW480 human colon cancer cell lines. Green Process. Synth. 2022, 11, 411–422. [Google Scholar] [CrossRef]
- Al-Zahrani, S.A.; Bhat, R.S.; Al-Onazi, M.A.; Alwhibi, M.S.; Soliman, D.A.; Aljebrin, N.A.; Al-Suhaibani, L.S.; Al Daihan, S. Anticancer potential of biogenic silver nanoparticles using the stem extract of Commiphora gileadensis against human colon cancer cells. Green Process. Synth. 2022, 11, 435–444. [Google Scholar] [CrossRef]
- Althomali, A.; Daghestani, M.H.; Almukaynizi, B.; Al-Zahrani, F.; Ahmed, S.; Awad, M.A.; Merghani, N.M.; Bukhari, W.I.; Ibrahim, E.M.; Alzahrani, S.M.; et al. Anti-colon cancer activities of green-synthesized Moringa oleifera–AgNPs against human colon cancer cells. Green Process. Synth. 2022, 11, 545–554. [Google Scholar] [CrossRef]
- Xi, Y.; Xu, P. Global colorectal cancer burden in 2020 and projections to 2040. Transl. Oncol. 2021, 14, 101174. [Google Scholar] [CrossRef] [PubMed]
- Zocche, D.M.; Ramirez, C.; Fontao, F.M.; Costa, L.D.; Redal, M.A. Global impact of KRAS mutation patterns in FOLFOX treated metastatic colorectal cancer. Front. Genet. 2015, 6, 116. [Google Scholar] [CrossRef]
- Deshmukh, S.P.; Patil, S.M.; Mullani, S.B.; Delekar, S.D. Silver nanoparticles as an effective disinfectant: A review. Mater. Sci. Eng. C Mater. Biol. Appl. 2019, 97, 954–965. [Google Scholar] [CrossRef]
- Osama, A.; AWdelkarim, S.; Fadul, E.; Mohamed, G.; Siddig, M.; Sheikh, A.; Abdelmoneim, A.; Khalid, A.; Hashesh, A.M. In vitro Evaluation of Acacia nilotica Pods for its Antioxidant, Acetylcholinesterase Inhibitory. Eur. Acad. Res. 2015, 3, 2286. [Google Scholar]
- Sadiq, M.B.; Tharaphan, P.; Chotivanich, K.; Tarning, J.; Anal, A.K. In vitro antioxidant and antimalarial activities of leaves, pods, and bark extracts of Acacia nilotica (L.) Del. BMC Complement Altern Med. 2017, 17, 372. [Google Scholar] [CrossRef]
- Ali, S.; Qaiser, M. Hybridization in Acacia nilotica (Mimosoideae) complex. Bot. J. Linn. Soc. 2008, 80, 69–77. [Google Scholar] [CrossRef]
- Yeshi, K.; Crayn, D.; Ritmejerytė, E.; Wangchuk, P. Plant Secondary Metabolites Produced in Response to Abiotic Stresses Has Potential Application in Pharmaceutical Product Development. Molecules 2022, 27, 313. [Google Scholar] [CrossRef]
- Jamloki, A.; Bhattacharyya, M.; Nautiyal, M.C.; Patni, B. Elucidating the relevance of high temperature and elevated CO2 in plant secondary metabolites (PSMs) production. Heliyon 2021, 7, e07709. [Google Scholar] [CrossRef] [PubMed]
- Zaarour, M.; El Roz, M.; Dong, B.; Retoux, R.; Aad, R. Photochemicalpreparation of silver nanoparticles supported on zeolite crystals. Langmuir Am. Chem. Soc. 2014, 30, 6250–6256. [Google Scholar]
- Maarebia, R.Z.; Wahab, A.W.; Taba, P. Synthesis and Characterization Of Silver Nanoparticles Using Water Extract of Sarang Semut (Myrmecodia pendans) For Blood Glucose Sensors. J. Akta Kim. Indones. (Indones. Chim. Acta) 2019, 12, 29–46. [Google Scholar] [CrossRef]
- Yguerabide, J.; Yguerabide, E.E. Light-scattering submicroscopic particles as highly fluorescent analogs and their use as tracer labels in clinical and biological applications. Anal. Biochem. 1998, 262, 137–156. [Google Scholar] [CrossRef]
- Bilal, M.; Rasheed, T.; Iqbal, H.M.; Li, C.; Hu, H.; Zhang, X. Development of silver nanoparticles loaded chitosan-alginate constructs with biomedical potentialities. Int. J. Biol. Macromol. 2017, 105, 393–400. [Google Scholar] [CrossRef]
- Rahman, A.; Kumar, S.; Bafana, A.; Lin, J.; Dahoumane, S.A.; Jeffryes, C. A Mechanistic View of the Light-Induced Synthesis of Silver Nanoparticles Using Extracellular Polymeric Substances of Chlamydomonas reinhardtii. Molecules 2019, 24, 3506. [Google Scholar] [CrossRef]
- Clayton, K.N.; Salameh, J.W.; Wereley, S.T.; Kinzer-Ursem, T.L. Physical characterization of nanoparticle size and surface modification using particle scattering diffusometry. Biomicrofluidics 2016, 10, 054107. [Google Scholar] [CrossRef]
- Velgosova, O.; Čižmárová, E.; Málek, J.; Kavuličova, J. Effect of storage conditions on long-term stability of Ag nanoparticles formed via green synthesis. Int. J. Miner. Metall. Mater. 2017, 24, 1177–1182. [Google Scholar] [CrossRef]
- Bhat, R.S.; Alghamdi, J.M.; Aldbass, A.M.; Aljebrin, N.A.; Alangery, A.B.; Soliman, D.A.; Al-Daihan, S. Biochemical and FT-IR profiling of Tritium aestivum L. seedling in response to sodium fluoride treatment. Fluoride 2022, 55, 81–89. [Google Scholar]
- Rai, M.K.; Deshmukh, S.D.; Ingle, A.P.; Gade, A.K. Silver nanoparticles: The powerful nano weapon against multidrug-resistant bacteria. J. Appl. Microbiol. 2012, 112, 841–852. [Google Scholar] [CrossRef]
- Nel, A.E.; Mädler, L.; Velegol, D.; Xia, T.; Hoek, E.M.V.; Somasundaran, P.; Klaessig, F.; Castranova, V. Understanding bio-physicochemical interactions at the nano-bio interface. Nat. Mater. 2009, 8, 543–557. [Google Scholar] [CrossRef] [PubMed]
- Hurley, M.M.; Martin, D.; Raisz, L.G. Changes in ethanol concentration during incubation in multiwell tissue culture trays. Proc. Soc. Exp. Biol. Med. 1987, 186, 139–141. [Google Scholar] [CrossRef]
- Koc, A.; Karabay, A.Z.; Ozkan, T.; Buyukbingol, Z.; Aktan, F. Time and concentration dependent effects of different solvents on proliferation of K562, HL60, HCT-116 and H929 cell lines. J. Res. Pharm. 2022, 26, 494–501. [Google Scholar] [CrossRef]
- Malik, P.; Shankar, R.; Malik, V.; Sharma, N.; Mukherjee, T. Green chemistry based benign routes for nanoparticle synthesis. J. Nanopart. 2014, 2014, 302429. [Google Scholar] [CrossRef]
- Hedberg, J.; Skoglund, S.; Karlsson, M.E.; Wold, S.; Odnevall Wallinder, I.; Hedberg, Y. Sequential studies of silver released from silver nanoparticles in aqueous media simulating sweat, laundry detergent solutions, and surface water. Environ. Sci. Technol. 2014, 48, 7314–7322. [Google Scholar] [CrossRef] [PubMed]
- Farah, M.A.; Ali, M.A.; Chen, S.-M.; Li, Y.; Al-Hemaid, F.M.; Abou-Tarboush, F.M.; Al-Anazi, K.M.; Lee, J. Silver nanoparticles synthesized from Adenium obesum leaf extract induced DNA damage, apoptosis, and autophagy via generation of reactive oxygen species. Colloids Surf. B Biointerfaces 2016, 141, 158–169. [Google Scholar] [CrossRef]
- Yang, T.; Yao, Q.; Cao, F.; Liu, Q.; Liu, B.; Wang, X.H. Silver nanoparticles inhibit the function of hypoxia-inducible factor-1 and target genes: Insight into the cytotoxicity and antiangiogenesis. Int. J. Nanomed. 2016, 11, 6679–6692. [Google Scholar] [CrossRef]
- Schatoff, E.M.; Leach, B.I.; Dow, L.E. Wnt signaling and colorectal cancer. Curr. Color. Cancer Rep. 2017, 13, 101–110. [Google Scholar] [CrossRef]
- Marcolino, T.F.; Pimenta, C.A.M.; Artigiani Neto, R.; Castelo, P.; Silva, M.S.; Forones, N.M.; Oshima, C.T.F. p53, Cyclin-D1, β-catenin, APC and c-myc in Tumor Tissue from Colorectal and Gastric Cancer Patients with Suspected Lynch Syndrome by the Bethesda Criteria. Asian Pac. J. Cancer Prev. 2020, 21, 343–348. [Google Scholar] [CrossRef]
- Seiler, R.; Thalmann, G.; Rotzer, D. CCND1/CyclinD1 status in metastasizing bladder cancer: A prognosticator and predictor of chemotherapeutic response. Mod. Pathol. 2014, 27, 87–95. [Google Scholar] [CrossRef] [PubMed]
- Thuringer, D.; Berthenet, K.; Cronier, L.; Solary, E.; Garrido, C. Primary tumor- and metastasis-derived colon cancer cells differently modulate connexin expression and function in human capillary endothelial cells. Oncotarget 2015, 6, 28800–28815. [Google Scholar] [CrossRef] [PubMed]
- Alamro, G.; Almousa, N.; Almusallam, J.; Watyan, M.B.; Alghamdi, S.; Al-Jabr, S.; Alqahtani, N.; Aldbass, A.; Bhat, R.S.; Daihan, S.A. Gene Expression Analysis of Specific Genes Related to Genomic Stability in Colon Cancer Cell Lines—A Resource for Cancer Research. J. Pharm. Res. Int. 2022, 34, 10–19. [Google Scholar] [CrossRef]
- Salvadores, M.; Fuster-Tormo, F.; Supek, F. Matching cell lines with cancer type and subtype of origin via mutational, epigenomic, and transcriptomic patterns. Sci. Adv. 2020, 6, eaba1862. [Google Scholar] [CrossRef] [PubMed]
- Nakamura, T.; Hamada, F.; Ishidate, T.; Anai, K.-I.; Kawahara, K.; Toyoshima, K.; Akiyama, T. Axin, an inhibitor of the Wnt signaling pathway, interacts with beta-catenin, GSK-3beta and APC and reduces the beta-catenin level. Genes Cells 1998, 3, 395–403. [Google Scholar] [CrossRef]
- Zhao, S.; Hao, C.-L.; Zhao, E.-H.; Jiang, H.-M.; Zheng, H.-C. The Suppressing Effects of Dkk3 Expression on Aggressiveness and Tumorigenesis of Colorectal Cancer. Front. Oncol. 2020, 10, 600322. [Google Scholar] [CrossRef]
- Alao, J.P. The regulation of cyclin D1 degradation: Roles in cancer development and the potential for therapeutic invention. Mol. Cancer 2007, 6, 24. [Google Scholar] [CrossRef]

| Primer | Sequence |
|---|---|
| GAPDH | F: AATGGGCAGCCGTTAGGAAA |
| R:GCCCAATACGACCAAATCAGAG | |
| CCND1 | F: ATCAAGTGTGACCCGGACTG |
| R: CTTGGGGTCCATGTTCTGCT | |
| C-MYC | F: TGGAAAACCAGCCTCCCG |
| R: TTCTCCTCCTCGTCGCAGTA | |
| CTNNB1 | F: GTAAAACGACGGCCAGTGGACTTCACCTGACAGATCCA |
| R: CAGGAAACAGCTATGACCAGCTCATCATCCAGCTCCAG | |
| APC | F: GACTCGGAAATGGGGTCCAA |
| R: TCTTCAGTGCCTCAACTTGCT | |
| BECN1 | F: GTAAAACGACGGCCAGTGCTGTTTGGAGATCTTAGAGCAA |
| R: CAGGAAACAGCTATGACCAGCTCATCATCCAGCTCCAG | |
| TP53 | F: GTAAAACGACGGCCAGTGTCTGGGCTTCTTGCATTCT |
| R: CAGGAAACAGCTATGACCCCAAATACTCCACACGCAAA | |
| DKK3 | F: GAAGGAGCCACGAGTGCAT |
| R: CAGTGACCCCAGACACACAG | |
| AXIN1 | F: GTGCCCCTACCTCACATTCC |
| R: CTCACCTTCCTCCTCCATGC |
| Wave Number (cm−1) | Probable Functional Group | |
|---|---|---|
| A. nilotica Extract | A. nilotica-AgNPs | |
| Lipids (3000–2800 cm−1) | ||
| 3754.10 | O__H stretch (Alcohols) | |
| 3368.82 | 3403.42 | N__H stretch (Amines) |
| Proteins (1700–1500 cm−1) | ||
| 1708.99 | 1706.32 | C=O (Saturated Aldehyde), C=C stretch (Benzene) |
| 1613.63 | 1619.44 | N__H bend (Nitro compounds, Amides), C__C stretch (Amides), C=O stretch (Carboxylic acid, Ketone), C=C (Benzene, Alkenes) |
| 1530.08 | 1526.04 | N__H bend (Nitro compounds), C__O stretch (Amides, Ketone), C=C (Benzene) |
| Carbohydrates (1500–1200 cm−1) | ||
| 1448.09 | 1445.75 | N=O stretch (Nitro compounds), CO__H bend (Aldehydes), O__H bend (Alcohols) |
| 1347.54 | 1347.58 | C__N stretch (Amines), C__O stretch (Esters), C__O stretch (Ethers, Alcohols), O__H band (Carboxylic acids) |
| 1201.23 | 1200.58 | C__N stretch (Amines), C__O stretch (Esters), C__O stretch (Ethers, Alcohols), O__H band (Carboxylic acids) |
| 1123.34 | 1123.95 | S=O stretch (Sulfoxides), C__N stretch (Amines), C__O stretch (Esters, Ether, Alcohol) |
| 1032.08 | 1030.88 | N__H bend (Nitro compounds, Amides), C__C stretch (Amides), C¼O stretch (Carboxylic acid, Ketone), C¼C (Benzene, Alkenes) |
| -Cell wall components and chlorophyll (1000–600 cm−1) | ||
| 865.77 | 866.56 | =C__H bend (Alkenes) (Pectin) |
| 757.09 | 756.84 | C__N stretch (Amines), =C__H bend (Benzene), C__C stretch (Chlorides) |
| 665.32 | C__N stretch (Amines), =C__H bend (Benzene), C__C stretch (Chlorides) | |
| Strains | Zone of Inhibition (mm) | |||
|---|---|---|---|---|
| Plant Extract | Biogenic AgNP | |||
| Gram +ive | S. aureus | 10 | 20 | |
| B. subtilis | 20 | 20 | ||
| S.epidermidis | 11 | 23 | ||
| S.pneumonia | 13 | 25 | ||
| Gram −ive | E. coli | 11 | 27 | |
| S. typhi | 12 | 25 | ||
| P. aeruginosa | 10 | 15 | ||
| K. pneumoniae | 15 | 18 | ||
Disclaimer/Publisher’s Note: The statements, opinions and data contained in all publications are solely those of the individual author(s) and contributor(s) and not of MDPI and/or the editor(s). MDPI and/or the editor(s) disclaim responsibility for any injury to people or property resulting from any ideas, methods, instructions or products referred to in the content. |
© 2023 by the authors. Licensee MDPI, Basel, Switzerland. This article is an open access article distributed under the terms and conditions of the Creative Commons Attribution (CC BY) license (https://creativecommons.org/licenses/by/4.0/).
Share and Cite
Alduraihem, N.S.; Bhat, R.S.; Al-Zahrani, S.A.; Elnagar, D.M.; Alobaid, H.M.; Daghestani, M.H. Anticancer and Antimicrobial Activity of Silver Nanoparticles Synthesized from Pods of Acacia nilotica. Processes 2023, 11, 301. https://doi.org/10.3390/pr11020301
Alduraihem NS, Bhat RS, Al-Zahrani SA, Elnagar DM, Alobaid HM, Daghestani MH. Anticancer and Antimicrobial Activity of Silver Nanoparticles Synthesized from Pods of Acacia nilotica. Processes. 2023; 11(2):301. https://doi.org/10.3390/pr11020301
Chicago/Turabian StyleAlduraihem, Nuha Suliman, Ramesa Shafi Bhat, Sabah Ahmed Al-Zahrani, Doaa M. Elnagar, Hussah M. Alobaid, and Maha H. Daghestani. 2023. "Anticancer and Antimicrobial Activity of Silver Nanoparticles Synthesized from Pods of Acacia nilotica" Processes 11, no. 2: 301. https://doi.org/10.3390/pr11020301
APA StyleAlduraihem, N. S., Bhat, R. S., Al-Zahrani, S. A., Elnagar, D. M., Alobaid, H. M., & Daghestani, M. H. (2023). Anticancer and Antimicrobial Activity of Silver Nanoparticles Synthesized from Pods of Acacia nilotica. Processes, 11(2), 301. https://doi.org/10.3390/pr11020301

